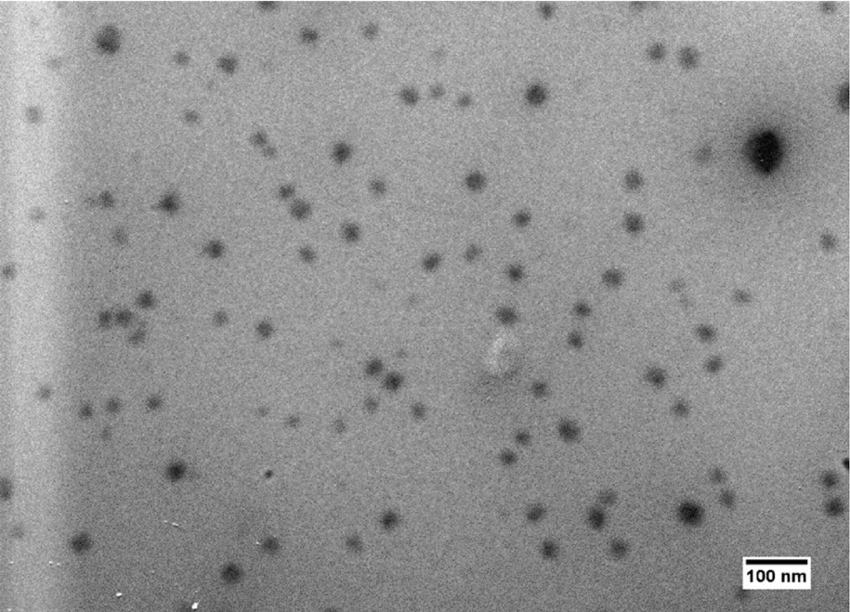

The 21st century’s food landscape is being fundamentally reshaped by nanoemulsion technology, a revolution occurring at the nanoscale. These ultra-fine dispersions, typically featuring droplets with diameters below 200 nanometers (nm)—and often below 100 nm—are not merely refined versions of traditional food emulsions like milk or mayonnaise. They represent a quantum leap in engineering food matrices for superior functionality, safety, and nutritional efficacy. Nanoemulsions harness the immense power of tiny size to fundamentally alter how we fortify, preserve, and consume food, moving beyond the limitations of macro-level ingredients.
The Nanoscale Advantage: Enhanced Bioavailability 🔬
One of the most significant breakthroughs of nanoemulsions lies in their ability to dramatically enhance the bioavailability of crucial, yet poorly soluble, lipophilic (fat-soluble) bioactive compounds. Vitamins, nutraceuticals, and antioxidants—such as Vitamin D, Vitamin E, Curcumin, and Omega-3 fatty acids—often struggle to be efficiently absorbed by the human body when delivered in their native oil form. Their low water solubility limits their uptake in the aqueous environment of the gastrointestinal tract.
Nanoemulsions solve this challenge through a massive increase in surface area-to-volume ratio. By reducing oil droplets to a fraction of a micron, the total interfacial surface area available for digestion by lipases and subsequent solubilization into mixed micelles increases exponentially. For instance, studies have shown that encapsulating Curcumin in a nanoemulsion can increase its aqueous solubility by up to 10,000-fold compared to its free form, leading to a demonstrable increase in absorption and biological effect in vivo. This technology transforms once-difficult-to-deliver nutrients into highly efficient, functional ingredients, thereby directly enhancing the nutritional profile of functional foods and beverages. The resulting nano-fortified products, such as fortified clear beverages or dairy alternatives, now offer maximized health benefits to the consumer.
Fortification Beyond Solubility: Clear Beverages and Novel Textures
The optical properties of nanoemulsions unlock entirely new product categories. When the droplet size is reduced to below approximately 50 nm, the droplets become too small to scatter visible light effectively, rendering the final solution optically transparent or translucent. This is a game-changer for fortifying beverages that demand a crystal-clear appearance, such as sports drinks, flavored waters, or clear energy shots, which cannot incorporate opaque or cloudy conventional emulsions.
Furthermore, nanoemulsions facilitate the incorporation of active ingredients without compromising sensory attributes. They can effectively mask the unpleasant tastes or odors of certain compounds, such as the fishy notes of Omega-3 fatty acids or the bitterness of some essential oils, by completely encapsulating them within the nano-droplets.
Beyond aesthetics, nanoemulsions also contribute to novel texture design in foods. Their high effective particle concentration allows for the formation of viscous or semi-solid systems at lower total fat content. This feature is being explored to create low-fat or fat-free dairy products, like yogurts or ice creams, that maintain the desirable creamy mouthfeel and textural consistency traditionally provided by higher fat levels, addressing the growing consumer demand for healthier indulgence.
Extending Shelf Life: A Stability and Antimicrobial Shield
The application of nanoemulsions as active agents for food preservation offers an elegant and powerful alternative to conventional chemical preservatives. The key to their enhanced preservation capability lies in two major mechanisms: superior physical stability and enhanced antimicrobial activity.
Physically, nanoemulsions are kinetically stable, showing far greater resistance to the primary causes of emulsion breakdown—such as creaming, sedimentation, flocculation, and coalescence—compared to micro- or macro-emulsions. This stability is attributed to the reduced gravitational forces and lower attractive forces between the tiny droplets, which minimizes aggregation. This property alone can extend the shelf life of beverages and liquid food products by months, protecting encapsulated vitamins and flavorings from degradation. For example, the protection against Ostwald ripening, a major instability pathway where small droplets diffuse into the aqueous phase and deposit onto larger droplets, is critical. Incorporating low-solubility ripening inhibitors within the oil phase further minimizes this effect.
More impressively, nanoemulsions are being formulated as potent antimicrobial and antioxidant delivery systems. By encapsulating natural preservatives like essential oils (e.g., Clove, Thyme, Cinnamon), nanoemulsions dramatically boost their efficacy. The nano-sized droplets significantly increase the effective surface area of the antimicrobial agent and, crucially, facilitate the transport of the lipophilic agent across the cell walls and membranes of foodborne pathogens, enabling a more direct and potent bactericidal action.
Edible Nanocoatings and Active Packaging: A Protective Layer
A major leap in post-harvest and food processing has been the development of nanoemulsion-based edible films and coatings. These coatings are created by incorporating antimicrobial and antioxidant nanoemulsions into a biopolymeric film (like chitosan or pectin) and applying them to the surface of fresh produce, meats, or cheeses.
These active coatings serve multiple functions simultaneously. They act as effective barriers to moisture and gas exchange, minimizing dehydration and slowing down oxygen-induced degradation like lipid oxidation and enzymatic browning (e.g., in cut fruits and vegetables). The active agents, such as antioxidants like $\alpha$-tocopherol (Vitamin E) or antibrowning agents like ascorbic acid, are released in a controlled manner, providing sustained protection throughout the product’s storage life. For instance, studies on fresh-cut apples and strawberries have shown that applying a nanoemulsion coating can reduce the browning index by over 50% and significantly inhibit microbial growth, potentially extending the product’s salable life by several days without relying on synthetic additives. The use of these nature-derived, nano-enhanced coatings aligns perfectly with the clean-label trend and the global focus on reducing food waste, establishing nanoemulsions as a cornerstone of sustainable food technology.
The Future Outlook: Commercial Scaling and Regulatory Focus
The commercial deployment of nanoemulsions is rapidly accelerating. High-energy methods, such as High-Pressure Homogenization (HPH)—capable of generating pressures in the range of 500 to 5000 psi—and low-energy methods, like the Phase Inversion Temperature (PIT) method, are now being scaled up for industrial production. HPH, in particular, is widely favored for its ability to produce highly uniform droplets at high throughput.
The key challenge remains the regulatory landscape and consumer perception. While many components used in food-grade nanoemulsions are Generally Recognized As Safe (GRAS), the nanotechnology itself demands careful scrutiny regarding long-term stability and any potential biological interactions in vivo. Research is continually advancing to utilize only natural and food-grade emulsifiers, such as phospholipids, proteins, and polysaccharides, to ensure the safety and clean-label appeal of the final products. As the technology matures, with an increasing number of nanoemulsion-fortified ingredients and products hitting global markets, the breakthroughs from the lab bench are now firmly establishing themselves as the standard for precision nutrition and advanced food preservation.
Leverage the power of nanoscale science to redefine your products. Our proprietary nanoemulsions, offering droplet sizes well below 100nm, ensure superior bioavailability for fat-soluble ingredients like CBD, Vitamin D, and Omega-3s—boosting nutritional efficacy up to 10,000-fold. Achieve crystal-clear, stable functional beverages and extended shelf life, preventing ingredient degradation and microbial spoilage. Meet the clean-label demand with enhanced stability, flavor masking, and natural preservation.
Stop compromising on formulation. Schedule a call with NanoHempTechLabs today to unlock the future of food fortification and stability.
Reference:
- Adlia, A., Aslan, C., Safitri, L., & Adnyana, I. (2025). Turmeric-black pepper-honey nanoemulsion formulation and antiulcerogenic effect evaluation against ethanol-induced gastric ulcers in rats. Plos One, 20(1), e0317899. https://doi.org/10.1371/journal.pone.0317899
- Bai, L., Huan, S., Rojas, O., & McClements, D. (2021). Recent innovations in emulsion science and technology for food applications. Journal of Agricultural and Food Chemistry, 69(32), 8944-8963. https://doi.org/10.1021/acs.jafc.1c01877
- Banasaz, S., Morozova, K., Ferrentino, G., & Scampicchio, M. (2020). Encapsulation of lipid-soluble bioactives by nanoemulsions. Molecules, 25(17), 3966. https://doi.org/10.3390/molecules25173966